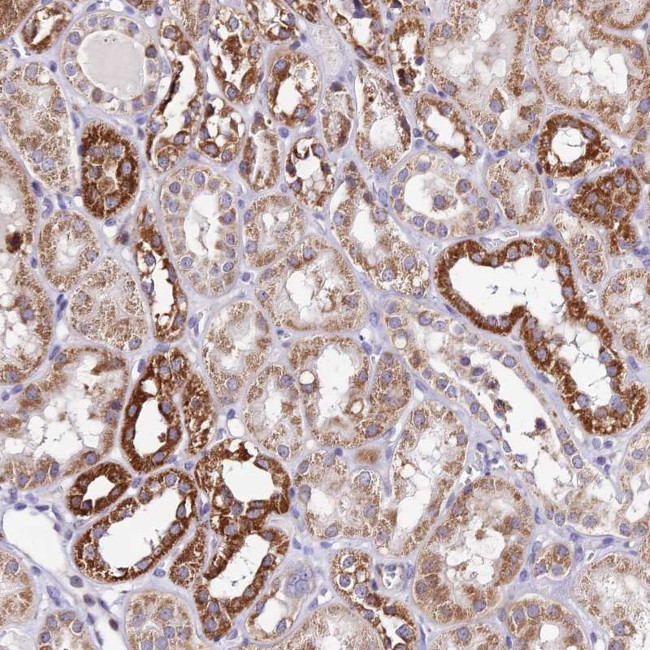
ATP Synthase B1 Antibody in Immunohistochemistry (Paraffin) (IHC (P))

Search
Invitrogen
ATP Synthase B1 Polyclonal Antibody
{{$productOrderCtrl.translations['antibody.pdp.commerceCard.promotion.promotions']}}
{{$productOrderCtrl.translations['antibody.pdp.commerceCard.promotion.viewpromo']}}
{{$productOrderCtrl.translations['antibody.pdp.commerceCard.promotion.promocode']}}: {{promo.promoCode}} {{promo.promoTitle}} {{promo.promoDescription}}. {{$productOrderCtrl.translations['antibody.pdp.commerceCard.promotion.learnmore']}}
产品信息
PA5-61141
种属反应
宿主/亚型
分类
类型
抗原
偶联物
形式
浓度
规格
纯化类型
保存液
内含物
保存条件
运输条件
RRID
产品详细信息
Immunogen sequence: QLEEAKQASI QHIQNAIDTE KSQQALVQKR HYLFDVQRNN IAMALEVTYR ERLYRVYKEV KN
Highest antigen sequence identity to the following orthologs: Mouse - 81%, Rat - 79%.
靶标信息
This gene encodes a subunit of mitochondrial ATP synthase. Mitochondrial ATP synthase catalyzes ATP synthesis, utilizing an electrochemical gradient of protons across the inner membrane during oxidative phosphorylation. ATP synthase is composed of two linked multi-subunit complexes: the soluble catalytic core, F1, and the membrane-spanning component, Fo, comprising the proton channel. The catalytic portion of mitochondrial ATP synthase consists of 5 different subunits (alpha, beta, gamma, delta, and epsilon) assembled with a stoichiometry of 3 alpha, 3 beta, and a single representative of the other 3. The proton channel seems to have nine subunits (a, b, c, d, e, f, g, F6 and 8). This gene encodes the b subunit of the proton channel.
仅用于科研。不用于诊断过程。未经明确授权不得转售。
篇参考文献 (0)
生物信息学
蛋白别名: ATP synthase B chain, mitochondrial; ATP synthase F(0) complex subunit B1, mitochondrial; ATP synthase peripheral stalk subunit b, mitochondrial; ATP synthase peripheral stalk-membrane subunit b; ATP synthase proton-transporting mitochondrial F(0) complex subunit B1; ATP synthase subunit b; ATP synthase subunit b, mitochondrial; ATP synthase, H+ transporting, mitochondrial F0 complex, subunit b; ATP synthase, H+ transporting, mitochondrial F0 complex, subunit B1; ATP synthase, H+ transporting, mitochondrial Fo complex subunit B1; ATPase subunit b; cell proliferation-inducing protein 47; H+-ATP synthase subunit b; PIG47; unnamed protein product
基因别名: ATP5F1; ATP5PB; PIG47
UniProt ID: (Human) P24539
Entrez Gene ID: (Human) 515